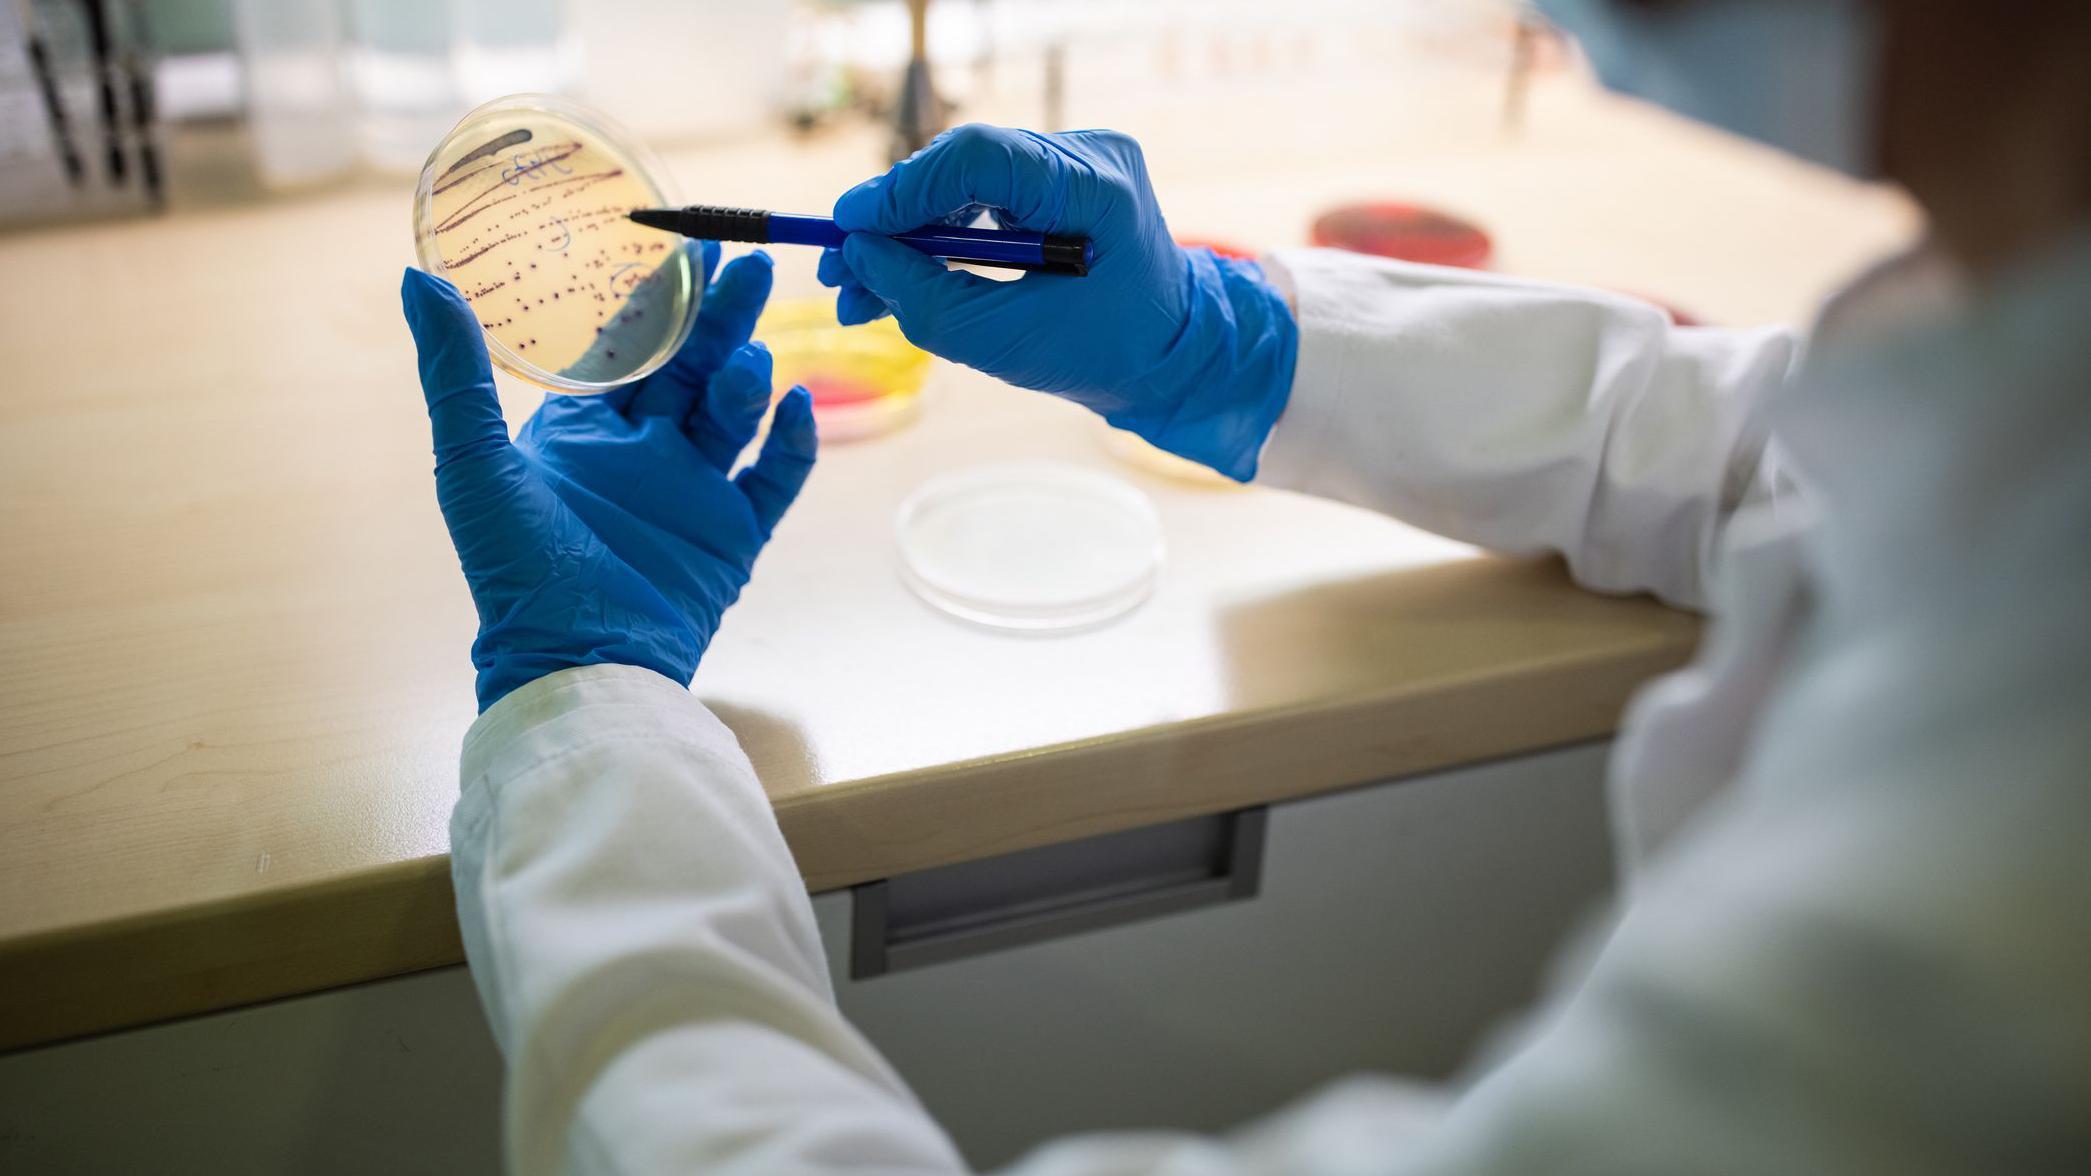
Microbióloga con guantes protectores sosteniendo una placa de Petri con un cultivo bacteriano en el laboratorio; lleva puesta una mascarilla protectora.

La oscuridad es total y la escasez de alimentos es extrema. Cualquier organismo que habite este lugar debe luchar por sobrevivir en condiciones cercanas a la inanición.
Hazel Barton, profesora de ciencias geológicas en la Universidad de Alabama, menciona: ‘Puedes acceder a una de las entradas y caminar durante 16 horas en una sola dirección antes de alcanzar el final’.
Barton continúa: ‘Estás realmente, realmente, realmente lejos de la entrada. Estás completamente aislado. Hay más personas que han caminado sobre la Luna que individuos que han explorado ciertos sectores de esa cueva’.
A pesar de la falta de luz, se puede encontrar una sorprendente variedad de vida microbiana.
Las bacterias, que han estado aisladas durante millones de años, proporcionan una perspectiva única del pasado. Además, cada una ha desarrollado métodos distintos para sobrevivir.
Algunas de estas bacterias obtienen energía de las rocas y la atmósfera, mientras que otras actúan como depredadoras alimentándose de otras bacterias.
Barton explica: ‘Al igual que en una selva tropical, observamos depredadores que se lanzan, atrapan, atacan y eliminan a otros microbios. Pero también hay microbios que colaboran para extraer nutrientes y energía de un sistema que no podría generar suficiente energía por sí solo para subsistir’.
Las bacterias también poseen una habilidad asombrosa: son resistentes a la mayoría de los antibióticos, a pesar de haber estado en una cueva que se formó hace seis millones de años, la cual permaneció en su mayoría aislada de los humanos hasta 1986.
Esta resistencia no solo es un fenómeno natural impresionante, sino que ahora está ayudando a los investigadores a desarrollar medicamentos que puedan enfrentar el aumento de la resistencia antimicrobiana en la medicina contemporánea.

Regresando un poco, en la actualidad, la aparición de bacterias resistentes a los antibióticos, comúnmente denominadas ‘superbacterias’, representa una creciente crisis de salud global.
Estas bacterias patógenas responsables de enfermedades han desarrollado resistencia a múltiples antibióticos, dificultando así el tratamiento de las infecciones.
Se determinó que la resistencia bacteriana a los antimicrobianos (RAM) fue responsable de 1,14 millones de muertes en 2021, y se estima que 39 millones de personas podrían fallecer a causa de la RAM entre 2025 y 2050.
Se estima que millones de niños mueren cada año debido a infecciones resistentes a los antibióticos.
La crisis de la RAM se suele atribuir al uso indebido y excesivo de antimicrobianos en humanos, animales y plantas. Sin embargo, esta no es toda la historia.
Un fenómeno que no es nuevo
En 2006, Gerard Wright, profesor de Bioquímica y Estudios Biomédicos en la Universidad McMaster de Ontario, descubrió bacterias en el suelo que estaban llenas de genes de resistencia a los antibióticos.
Estos microbios presentes en el lodo poseían exactamente los mismos genes de resistencia que las bacterias que causan enfermedades en humanos.
Wright afirma: ‘No eran bacterias patógenas. No causaban enfermedades. Simplemente existían, sin causar problemas’.
Esto sugería que la resistencia a los antimicrobianos no era un fenómeno reciente y que, de hecho, estaba presente en muchas bacterias.
Este descubrimiento se vio respaldado por el hallazgo de bacterias resistentes en núcleos de hielo glaciar de la Antártida, así como en los suelos, mares y rocas de este continente aislado.
Además, se han encontrado bacterias resistentes a los antimicrobianos en el permafrost antiguo, así como en la microbiota intestinal de los miembros de una tribu aislada de la selva amazónica.
Sin embargo, el hallazgo de Wright por sí solo no bastó para convencer a la comunidad científica de que la resistencia a los antimicrobianos había surgido sin contacto humano.
Al fin y al cabo, el uso excesivo de antibióticos en la agricultura está bien documentado. Las bacterias del suelo podrían haber entrado en contacto con los antibióticos de esta manera.
“Vivimos en la era antropogénica, así que no hay lugar que no tenga evidencia de actividad humana, ya sea en la cima del Everest o en el fondo de la Fosa de las Marianas”, concluye Wright.
Lo que se necesitaba era un entorno prístino, aislado de la actividad humana durante milenios. Así surgió la cueva de Lechuguilla.
Esta cueva se formó hace millones de años a partir del agua de lluvia que se filtraba a gran profundidad. El agua se combinó con sulfuro de hidrógeno en las profundidades de la Tierra, creando ácido sulfúrico.
Este ácido ascendió a gran presión, disolviendo la piedra caliza a su paso. Finalmente, el agua rica en ácido chocó contra una capa de arenisca insoluble.
“Debido a esa capa de roca, nada puede entrar en la cueva”, explica Barton.
“Las cuevas se formaron hace millones de años, y el agua superficial tarda unos 1.000 años en llegar a la zona donde estábamos tomando muestras. Además, era un pasaje recién descubierto al que, según sabemos, ningún ser humano había accedido antes”.
En otras palabras, no hay posibilidad de que antibióticos hayan llegado a las cuevas.
Barton lleva más de 20 años estudiando la vida microscópica en cuevas. Es una de las pocas personas con acceso a la cueva de Lechuguilla.
Por ello, en 2012, se unió a Wright para investigar si estos microbios también podrían ser resistentes a los antibióticos.
Barton descendió a la cueva de Lechuguilla para recoger muestras. La cueva tiene más de 366 metros de profundidad, por lo que para obtener las muestras fue necesario descender en rápel por una docena de cuerdas. Sin embargo, el esfuerzo valió la pena.
“Como era de esperar, descubrimos que todos los microbios presentes eran resistentes a prácticamente todos los antibióticos naturales que se han utilizado en la práctica clínica”, afirma Barton.
Esto tiene sentido desde una perspectiva evolutiva.
Competencia de millones de años
“Los mecanismos y las vías que conducen a la resistencia a los antibióticos no se forman rápidamente”, explica Barton.
“Si observamos la estructura de un antibiótico, vemos que se trata de una molécula que probablemente tardó cientos de millones, si no miles de millones, de años en formarse, por lo que es probable que la resistencia a estos antibióticos sea tan antigua como los propios antibióticos”.
Sin embargo, las bacterias seguían siendo eliminadas por antibióticos sintéticos o semisintéticos, ya que nunca habían estado expuestas a ellos.
Un microbio, una cepa bacteriana no patógena llamada Paenibacillus sp. LC231, era resistente a 26 de los 40 antibióticos analizados, incluida la daptomicina, un antibiótico relativamente nuevo que se considera un último recurso contra bacterias resistentes a los medicamentos como el Staphylococcus aureus resistente a la meticilina (SARM).
Los investigadores secuenciaron el genoma completo de Paenibacillus sp. LC231 y descubrieron que muchos de los genes de resistencia eran idénticos a los encontrados en bacterias conocidas resistentes a los antibióticos.
Sin embargo, el equipo también identificó cinco genes de resistencia que nunca antes se habían detectado.
Curiosamente, una especie emparentada con el antiguo y aislado Paenibacillus —una especie formadora de esporas que se encuentra ampliamente distribuida en la superficie— también posee los mismos mecanismos de resistencia.
Esto significa que la resistencia a los antibióticos evolucionó antes de que las bacterias quedaran atrapadas en la cueva, no después.
“La conclusión principal para nosotros, y la razón por la que intentábamos hacer esto, era demostrar que la resistencia a los antibióticos forma parte de la historia natural de los microorganismos en el planeta”, afirma Wright.
“La mayoría de los antibióticos provienen de bacterias y hongos, por lo que llevan produciéndolos y compitiendo entre sí durante cientos de millones, si no miles de millones de años”.

Según Wright, durante la mayor parte de la historia de la Tierra, la resistencia a los antibióticos se ha limitado a cepas bacterianas no patógenas, es decir, aquellas que no causan enfermedades.
Sin embargo, nuestro uso generalizado de antibióticos para tratar infecciones ha ejercido una fuerte presión selectiva que ha impulsado a los microbios patógenos a adoptar también estas defensas.
Dado que las bacterias pueden transmitir genes rápidamente entre sí, la resistencia antimicrobiana se ha propagado con rapidez.
No obstante, es posible que el entorno hostil de las cuevas haya propiciado que las bacterias conserven y perfeccionen sus defensas.
Como los nutrientes y los recursos son tan escasos, las bacterias deben competir entre sí para sobrevivir, afirma Barton. Es probable que se produzca una guerra microbiana.
“Si se reduce la cantidad de recursos disponibles para una comunidad, esta se volverá mucho más agresiva y habrá mucha más lucha interna entre los microbios”, explica Barton.
Como era de esperar, los biólogos encontraron microbios en las cuevas que liberaban antibióticos sin control. Una muestra produjo 38 compuestos antimicrobianos diferentes, con tres estructuras antibióticas novedosas.
La utilidad del descubrimiento
¿Podríamos usar este nuevo conocimiento para ayudarnos en la lucha contra la resistencia a los antimicrobianos?
Es posible que descubrir el valioso arsenal secreto de las bacterias ayude a desarrollar nuevos tratamientos.
Tradicionalmente, los científicos han descubierto nuevos antibióticos explorando la naturaleza, tomando muestras de agua y suelo, y tratando minuciosamente de purificar y extraer los compuestos que podrían ser beneficiosos.
En 2025, Wright y sus colegas descubrieron una nueva y prometedora clase de antibióticos en el suelo.
Encontrar bacterias en áreas aisladas e inexploradas podría ser útil, ya que es posible que los microbios de las cuevas produzcan antibióticos ancestrales contra los que las bacterias de la superficie hayan olvidado cómo defenderse, o que ni siquiera hayan encontrado.
Naowarat (Ann) Cheeptham, microbióloga de la Universidad Thompson Rivers en Canadá, se propone hacer precisamente eso.
Durante la última década, el equipo de Cheeptham ha explorado cuevas, tomado muestras de suelo y cultivado las bacterias resultantes en placas de Petri.
Posteriormente, se realizaron pruebas con estas bacterias contra superbacterias conocidas para determinar si los microbios de las cuevas podían eliminarlas.
Hasta la fecha, Cheeptham ha analizado más de 2.000 bacterias y ha identificado muchos candidatos prometedores.
Por ejemplo, su equipo encontró dos especies de bacterias en la Cueva del Telón de Acero, en Canadá, capaces de eliminar cepas de Escherichia coli multirresistentes.
También descubrió cinco microbios en la Cueva del Conejo Blanco, ubicada en la cordillera de Monashee, en el centro-sur de la Columbia Británica, que producían antibióticos eficaces contra el SARM.

Sin embargo, la falta de financiación para la investigación del descubrimiento de antibióticos la ha llevado a pausar su búsqueda de nuevos fármacos, al menos por ahora.
“Encontramos compuestos potenciales, pero nos llevará mucho tiempo e inversión financiera llegar al punto en que las compañías farmacéuticas colaboren con nosotros”, dice Cheeptham.
“Estos [los candidatos prometedores] aún están en fase de investigación, así que cuando tengamos fondos, los retomaremos”.
Como alternativa, los microbios de las cuevas podrían ayudar en la lucha contra la resistencia a los antimicrobianos (RAM) al permitir a los científicos predecir cuándo las bacterias podrían desarrollar resistencia a una nueva clase de antibióticos.
“Lo primero que hay que saber es cuáles son los mecanismos de resistencia que ya existen”, dice Wright.
“Porque si voy a descubrir un antibiótico mañana y quiero llevarlo a la clínica, sería buena idea comprender cuáles son sus limitaciones, cuáles son sus vulnerabilidades ante lo que ya existe, porque así estaremos mejor preparados para la aparición de la resistencia, no si ocurrirá, sino cuando ocurra”.
Los mecanismos comunes de resistencia incluyen bombas simples que expulsan el antibiótico de la bacteria. Otros implican enzimas mucho más complejas que modifican o degradan los antibióticos.
Conocer cómo una bacteria destruye el antibiótico podría ayudar a los científicos a diseñar nuevos fármacos para superar sus defensas.
Por ejemplo, la penicilina por sí sola a menudo deja de ser efectiva, porque muchas bacterias poseen una enzima que se une al antibiótico y lo inactiva. Sin embargo, si se añade un compuesto llamado ácido clavulánico, esta molécula se une a la enzima y la inhibe.
Así, al añadir ácido clavulánico a la penicilina, se contrarresta el mecanismo de resistencia y la penicilina vuelve a ser efectiva. Se espera que la identificación de procesos similares en bacterias de cuevas pueda brindar a los investigadores médicos una gran ventaja.
“Al descubrir qué mecanismo podría usar un microorganismo para superar un antibiótico, se puede encontrar la manera de combatirlo antes de que llegue a la clínica”, afirma Barton.
Este artículo apareció en BBC Earth. Puedes leer la versión original en inglés

para leer más historias de BBC News Mundo.
a nuestro nuevo newsletter para recibir cada viernes una selección de nuestro mejor contenido de la semana.
También puedes seguirnos en , , , , y en nuestro .
Y recuerda que puedes recibir notificaciones en nuestra app. Descarga la última versión y actívalas.
Gracias por acompañarnos hasta el final de esta historia.
Desde Referente Guatemala Creemos que la información también nos ayuda a comprendernos mejor como sociedad y a observar con mayor atención lo que ocurre a nuestro alrededor.








